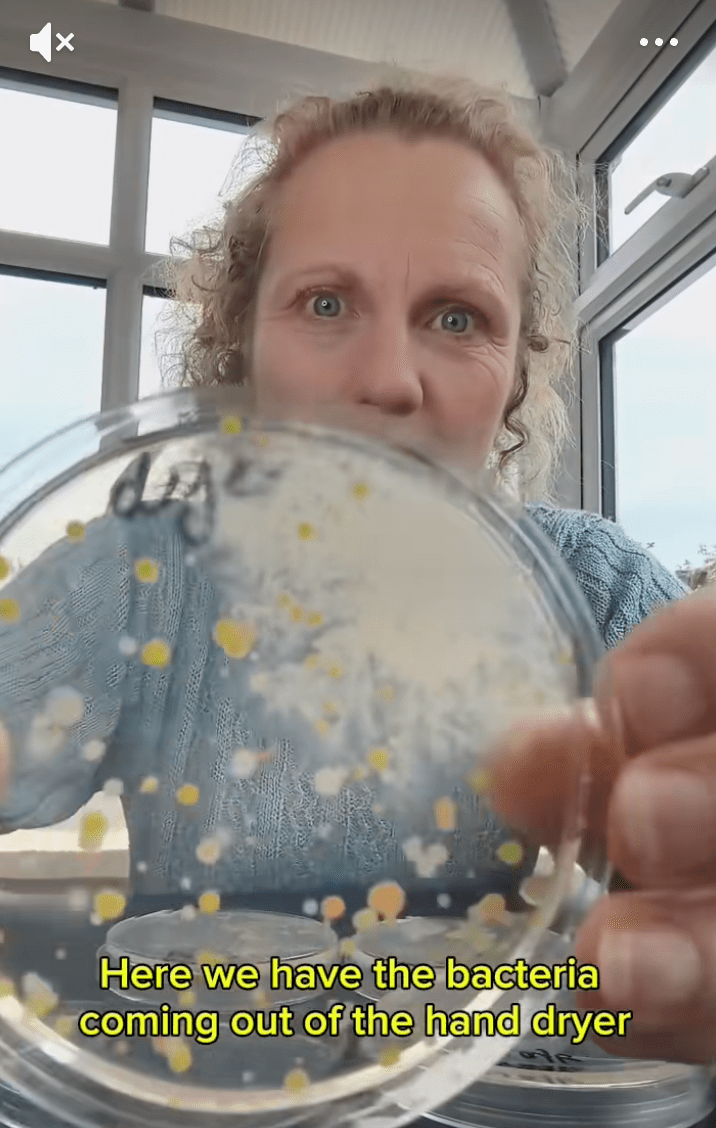
实验揭公厕烘手机藏菌惊人 用后肮脏过未洗手前 影片破千万观看掀热议

实验揭公厕烘手机藏菌惊人 用后肮脏过未洗手前 影片破千万观看掀热议




(伦敦9日综合民)英国教育机构“Devon Science”创办人、科学家卢思麦克拉伦近日在社媒上分享一项震撼实验,揭示公共厕所烘手机吹出的风中竟充满细菌与真菌,经一夜培养后,培养皿上长满多种细菌菌落,对照之下,一般空气样本几乎“零生长”,结果令她直言:“这就是我不用烘手机的原因。”影片上传后疯传,累积观看次数突破1000万,引发全球网民热议。
英国《Devon Live》报道,麦克拉伦将培养皿放在公厕烘手机下方收集吹出的空气,同时以另一皿在普通空气中挥动作对照。经过隔夜培养,结果发现烘手机样本长出大量细菌与真菌,对照组则几乎没有菌落。她后来又进行更严谨的对照实验,分别采集烘手机出风口、厕所空气、洗手前的手及洗完手后用烘手机的手,共4个样本。结果显示,烘手机出风口的细菌量最多,其次竟是“洗完手后再烘干的手”,菌量比未洗手前还要多。
ADVERTISEMENT


影片曝光后,许多网民惊呼“以后不敢用烘手机了”,甚至有人留言:“我宁愿用衣服擦手,也不想被吹一脸细菌。”另有网友质疑实验未足科学,指出厕所烘手机的采集样本不够多,并建议同时测试纸巾擦手或自然风干的效果。
部分医学专家呼吁公众毋须过度恐慌,表示无论使用纸巾或烘手机,只要洗手步骤确实、能彻底烘干或擦干,手部细菌量便可大幅降低。真正关键在于“洗手是否正确”而非仅限于烘手机或纸巾孰优孰劣。
虽然科学界对烘手机是否会二次污染仍有争议,但是麦克拉伦的实验无疑再度唤起公众对公厕卫生的关注,也让不少人重新审视每日看似微不足道的洗手习惯。
ADVERTISEMENT
热门新闻





百格视频





ADVERTISEMENT
































